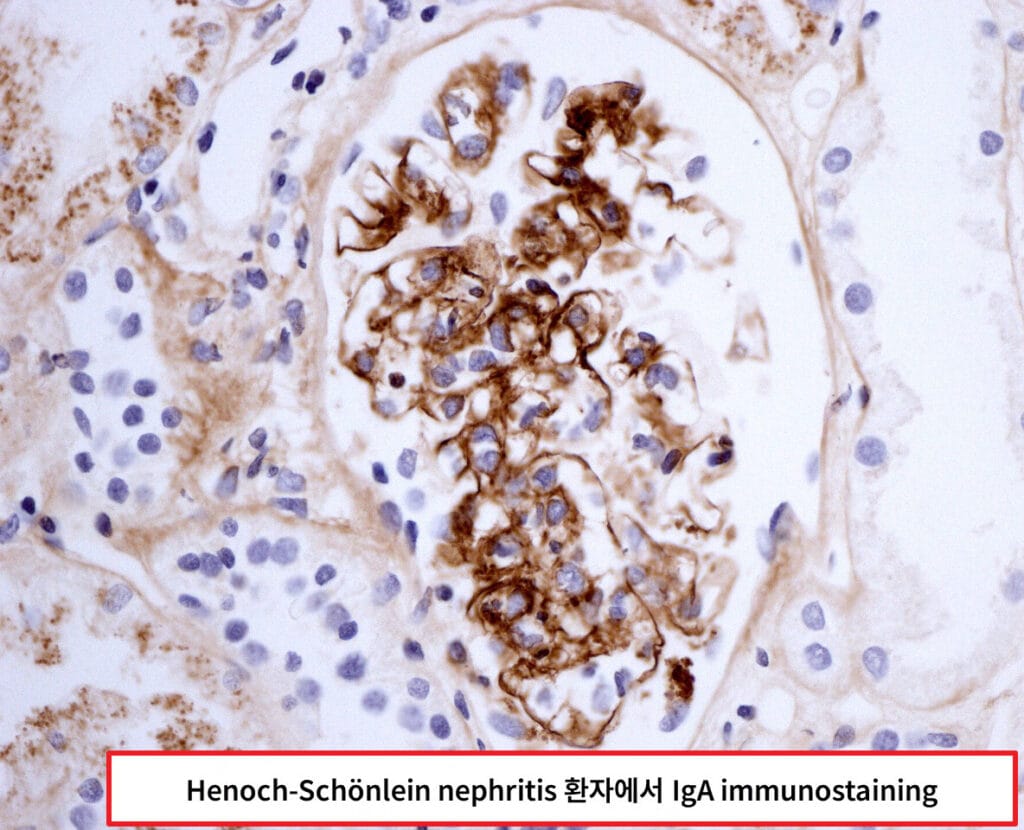

Table of Contents
헤노흐-쉔라인 자반증 (Henoch-Schönlein Purpura)
헤노흐-쉔라인 자반증(Henoch-Schönlein Purpura, HSP)은 소혈관(모세혈관, 세정맥 등)의 염증으로 인해 피부, 관절, 위장관, 신장 등에 자반과 출혈이 나타나는 자가면역 질환입니다. 주로 IgA 면역복합체가 혈관에 침착되어 혈관염을 일으킵니다.

소아에서 흔히 발생하며, 피부에 자반이 나타나고 복통, 관절통, 혈뇨 등이 동반됩니다.
| 헤노흐-쉔라인 자반증 (Henoch-Schönlein Purpura) |
| 🟦 IgA 면역복합체가 소혈관에 침착되어 혈관염을 일으키며 자반과 통증, 신장병증 등을 유발합니다. |
원인
정확한 원인은 밝혀지지 않았으나 감염 후 면역 반응이 주된 유발 요인으로 작용합니다.
| 주요 원인 |
| 🔴 상기도 감염 |
| 감기나 인두염 등 바이러스 또는 세균 감염 이후 면역 반응으로 IgA가 과다 생성되어 혈관에 침착됩니다. |
| 🔴 백신 접종 후 |
| 드물게 백신 자극에 의한 면역반응이 관여할 수 있습니다. |
| 🔴 약물 반응 |
| 페니실린 등 특정 약물이 면역계 자극을 유발하여 IgA 침착을 초래할 수 있습니다. |
| 🔴 음식 또는 곤충자극 |
| 알레르기 반응과 유사하게 면역계가 활성화되어 자가면역 반응을 유도할 수 있습니다. |
임상양상
피부 자반을 포함하여 복부, 관절, 신장을 침범할 수 있습니다.
하지에 대칭성 자반이 나타나고, 복통과 관절통, 혈뇨가 흔하게 동반됩니다.
| 증상 및 징후 |
| 🟨 자반 (Palpable purpura) |
| 주로 엉덩이, 다리 등 하체에 나타나며, 피부를 눌러도 사라지지 않고 만져지는 성상입니다. |
| 🟨 복통 및 위장관 출혈 |
| 장 점막의 혈관염으로 장벽 출혈, 복통, 혈변 등이 나타납니다. 장중첩증의 위험도 있습니다. |
| 🟨 관절통 (Arthralgia) |
| 무릎, 발목 등 큰 관절 위주로 통증이 있으며, 관절 부종을 동반할 수 있습니다. |
| 🟨 혈뇨 또는 단백뇨 |
| 신장 침범 시 사구체염이 발생하여 혈뇨, 단백뇨가 나타나며, 드물게 신증후군으로 진행할 수 있습니다. |


진단
임상증상에 기반한 진단이 원칙이며, IgA 관련 검사와 조직검사를 통해 확진할 수 있습니다.
| 진단 방법 |
| 🔵 임상적 기준 (EULAR/PRINTO/PRES 기준) |
| 피부 자반이 반드시 존재하고, 복통, 관절통, 신장침범, 조직검사 중 1가지 이상이 동반되면 진단합니다. |
| 🔵 혈액검사 (IgA 상승) |
| 혈청 IgA 수치가 상승해 있는 경우가 많으며, 염증수치(ESR, CRP)도 상승할 수 있습니다. |
| 🔵 소변검사 |
| 혈뇨, 단백뇨 등 신장 침범 여부를 확인합니다. |
| 🔵 피부 또는 신장 조직검사 |
| 면역형광염색에서 IgA 침착을 확인하면 확진 가능합니다. |

치료
대부분 자연적으로 회복되며, 증상에 따라 대증치료 또는 면역억제 치료를 시행합니다.
경증은 대증치료로 충분하며, 신장 침범이나 중증 위장관 증상이 있으면 스테로이드를 고려합니다.
대증 치료
통증 조절 및 수분 보충 등 증상 완화를 목표로 합니다.
| 대증 치료 |
| 🔵 수액 보충 및 통증 조절 |
| 복통, 관절통 조절을 위한 진통제(NSAIDs), 수액 치료 등 보존적 치료가 필요합니다. |
약물 치료
중등도~중증 환자에는 스테로이드 등 면역억제제를 고려할 수 있습니다.
| 약물 치료 |
| 💊 프레드니솔론 (Prednisolone) |
| 복통, 관절통, 피부 병변 완화에 효과적이며 신장 침범 초기에도 사용됩니다. |
| 💊 사이클로포스파마이드 (Cyclophosphamide) |
| 중증 신장염이나 스테로이드에 반응하지 않는 경우 사용합니다. |
| 💊 아자티오프린 (Azathioprine) |
| 스테로이드 감량이 어려운 경우 스테로이드 sparing 목적 등으로 사용됩니다. |
예후
대부분 수주 내 자연 회복되나, 신장 합병증은 장기 추적이 필요합니다.
| 예후 |
| 🟧 피부, 관절 증상만 있는 경우 대부분 1~2개월 내 완전 회복됩니다. |
| 🟧 신장 침범이 있을 경우 수개월~수년간 단백뇨/혈뇨 지속될 수 있으며 드물게 만성 신부전으로 진행할 수 있습니다. |
생활 관리
증상 악화 방지 및 재발 감시를 위해 생활 습관 및 추적 관찰이 중요합니다.
| 생활 관리 수칙 |
| 🟨 격렬한 운동 피하기 |
| 복통이나 출혈 증상 악화 가능성이 있어 증상 있는 기간 동안에는 안정이 필요합니다. |
| 🟨 정기적인 소변검사 |
| 신장 합병증 조기 발견을 위해 수개월간 주기적 소변검사를 시행합니다. |
| 🟨 약물 복용 순응도 유지 |
| 스테로이드 등 복용 시 증상 개선 여부와 부작용을 면밀히 관찰합니다. |



